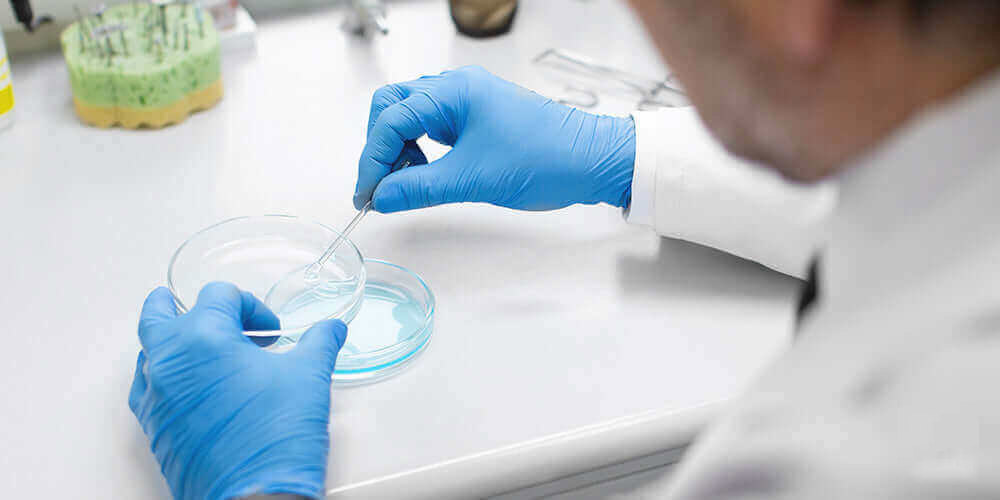
Дослідження безпеки та ефективності прийому NMN на клітинному метаболізмі

Дозування NMN — це ключове питання для всіх, хто хоче отримати максимальну користь від нікотинаміду мононуклеотиду. Правильне дозування NMN допомагає підвищити рівень NAD+ (нікотинамідаденіндинуклеотид) в організмі, що є важливим коферментом для підтримки здоров’я наших клітин, особливо з віком.
Добавки NMN стали дуже популярними, оскільки вони потенційно можуть підвищити рівень NAD+ в організмі та підтримати здоровий процес старіння. Визначення правильного дозування є ключем до максимізації цих переваг без шкоди для безпеки.
Добавки NMN випускаються в різних форматах і розмірах порцій, від 100 до 1000 мг. Хоча ми не можемо передбачити, що працюватиме найкраще саме для вас, ми підготували детальний гід з дозування NMN на основі наших власних досвідів та доступних досліджень.
Рекомендоване дозування NMN
Рекомендоване дозування NMN становить від 250 мг на день для початківців до 900 мг щодня для досвідчених користувачів. Не перевищуйте 1200 мг NMN на день — це максимальна безпечна доза. Ідеальне дозування NMN залежить від індивідуальних факторів, які впливають на потребу в NMN, включаючи вік, метаболізм, дієту та спосіб життя.
На основі доступних досліджень та відгуків споживачів ми підготували загальний огляд стандартного дозування NMN та рекомендацій.

Початкове дозування: 250 мг
Для тих, хто вперше починає приймати добавки NMN, часто рекомендується початкове дозування близько 250 мг на день.
Це дозування NMN забезпечує базовий рівень NMN, який може допомогти підвищити рівень NAD+ без перевантаження системи, як було показано у здорових людей середнього віку під час 12-тижневого випробування.
Щоденна доза 250 мг у літніх дорослих була пов’язана з кращим настроєм, концентрацією та швидкістю ходьби.
Це хороша відправна точка, щоб оцінити, як ваш організм реагує на прийом NMN.
Для кого: Нові користувачі, здорові дорослі середнього віку (35 років і молодше)

Помірне дозування: 500-1000 мг
Помірне дозування NMN, що коливається від 500 мг до 1000 мг на день, є поширеним серед регулярних користувачів NMN. Дослідження часто цитують ці дози як ефективні для підвищення рівня NAD+ та підтримки клітинної енергії та довголіття.
Дозування NMN у цьому діапазоні вважається безпечним та корисним для людей, особливо літніх дорослих (60+), які прагнуть підтримувати стабільні рівні NAD+ для довгострокових переваг здоров’я.
Один із простих способів підтримувати цей діапазон дозування — обрати добавку NMN, що містить 500 мг на порцію. Протягом кількох тижнів, якщо ви бачите переваги цієї дози, ви можете збільшити споживання до 1000 мг на день.
Для кого: Регулярні користувачі NMN, дорослі 35-60 років, ті, хто шукає довгострокову підтримку здоров’я

Високе дозування: 1000-1200 мг
Вищі дози, такі як від 1000 мг до 1200 мг щодня, іноді використовуються для більш інтенсивної підтримки літніх людей. З віком рівні NAD+ природно знижуються, що пов’язано зі змінами у виробництві клітинної енергії та загальному метаболізмі.
Дослідження припускають, що вище дозування NMN може допомогти підтримувати рівні NAD+, підтримувати клітинні процеси, пов’язані з енергетичним метаболізмом, та захищати ДНК.
Спортсмени — це ще одна група, яка часто шукає вище дозування NMN через їхні підвищені метаболічні вимоги. Вищі рівні NAD+ пов’язані з підтримкою витривалості та відновлення, що є важливим для спортивних результатів.
Ці дозування можуть забезпечити найбільший приріст рівнів NAD+, але їх слід використовувати обережно. Більше не завжди означає краще, особливо якщо ваш організм ще не звик до доз NMN.
Хороша новина полягає в тому, що добавки NMN добре переносяться в дозах до 1200 мг щодня.
Для кого: Дорослі 60+ років, спортсмени, ті, хто потребує інтенсивної підтримки NAD+
Таблиця рекомендованого дозування NMN
| Доза | Рекомендовано для | Опис |
|---|---|---|
| 250 мг | Нові користувачі, Здорові дорослі середнього віку | Забезпечує базові рівні NMN. Підвищує NAD+ без перевантаження системи. Покращує настрій, сон та швидкість ходьби у літніх дорослих. |
| 500-1000 мг | Регулярні користувачі NMN, Дорослі 60+ | Підвищує рівні NAD+ та підтримує клітинну енергію і довголіття. Безпечне та корисне для літніх дорослих. Ефективне для довгострокового здоров’я. |
| 1000-1200 мг | Літні люди, Спортсмени | Підтримує рівні NAD+, підтримує клітинні процеси та захищає ДНК. Підходить для літніх дорослих та спортсменів. Забезпечує найбільший приріст NAD+. Слід використовувати обережно. |
Дозування NMN за віком
Правильне дозування NMN залежить від вашого віку та метаболічних потреб:
🔹 До 35 років: 250 мг на день — ідеально для підтримки базових рівнів NAD+ без перестимуляції
🔹 35-60 років: 500-1000 мг на день — підвищує виробництво NAD+, клітинну енергію та підтримує довгострокове здоров’я
🔹 60+ років: 1000-1200 мг на день — компенсує більше зниження NAD+, підтримує відновлення ДНК та клітинні процеси
Як приймати NMN?
Ви можете приймати NMN сублінгвально, перорально або через порошки — всі вони дають вам можливість приймати продукти у розділених дозах.
Ми пропонуємо різні форми NMN, включаючи: капсули, порошки, настойки, жувальні цукерки та креми.

Різні форми добавок NMN
1. Капсули/Таблетки
Найпоширеніша форма — це капсули, які легко приймати з водою, і вони пропонують попередньо виміряну дозу для зручності. Ковтайте капсулу або таблетку цілою — не роздавлюйте і не жуйте — зі склянкою води.
Переваги: Зручність, точне дозування NMN, легко брати з собою
2. Порошок
Порошок NMN можна змішувати в смузі, воду або інші напої. Цей метод дозволяє гнучке дозування NMN. Більшість порошків NMN зазвичай не мають смаку, але вони можуть додати зернисту текстуру до ваших напоїв, залежно від того, наскільки дрібний порошок.
Переваги: Гнучке дозування, можна додавати в напої
3. Настойка (Tincture)
По суті, це порошок NMN, розчинений у воді, спирті або гліцериновій основі, призначений для сублінгвального прийому (під язиком) для швидшого всмоктування. З настойками ви також маєте більшу гнучкість з дозуванням NMN, але смак формули може деяких людей відштовхнути.
Переваги: Швидке всмоктування, гнучке дозування
4. Жувальні цукерки (Gummies)
Жувальні цукерки NMN не такі поширені, але вони є смаколиком, коли ви можете їх дістати. Вони поєднують попередньо встановлену дозу NMN з формулою жувальної цукерки, що може бути кращим варіантом для тих, хто не може ковтати таблетки, але хоче зручності попередньо виміряних доз NMN.
Переваги: Приємний смак, зручність, точна доза
5. Креми
NMN може бути сформульований у засоби для догляду за шкірою, що дозволяє отримати локалізовані переваги та системне всмоктування. Їх також не так легко знайти, але вони зазвичай призначені для боротьби з дрібними зморшками, зморшками та іншими ознаками старіння.
Переваги: Локальна дія на шкіру, антивікові властивості



Коли приймати NMN? Час прийому
Час прийому не так важливий, як щоденний прийом вашого NMN, оскільки послідовність є ключовою для підтримки ваших рівнів NAD+. Деякі люди клянуться, що приймають NMN вранці на порожній шлунок для максимального всмоктування, що узгоджується з природними циркадними ритмами організму.
Однак деякі дослідження у молодих дорослих також припускають, що прийом NMN через 6 годин після пробудження (приблизно в обідній час) набагато більш корисний.
Рекомендації щодо часу прийому:
✅ Ранок (натщесерце) — максимальне всмоктування, узгодження з циркадними ритмами
✅ Обід (через 6 годин після пробудження) — показано ефективність у молодих дорослих
✅ Головне — регулярність — приймайте в один і той же час щодня для стабільних рівнів NAD+
Різниця між дозуванням NMN для тварин та людей
Дослідження безпеки та ефективності прийому NMN на клітинному метаболізмі, старінні та загальному здоров’ї часто починаються з досліджень на тваринах, особливо на мишах. Ці дослідження надають цінну інформацію, але представляють виклики при перекладі результатів на відповідні дози для людей.
Різниця в дозуванні добавок
У дослідженнях на тваринах дози NMN зазвичай вищі відносно маси тіла суб’єкта. Наприклад, дослідження може використовувати дози в діапазоні від 100-300 мг/кг щодня. NMN зазвичай вводиться через воду або їжу.
Клінічні випробування на людях
Дослідження на людях використовують значно нижчі дозування, скориговані відповідно до їхньої різниці у масі тіла. Поширені дози, що спостерігаються в дослідженнях, коливаються від 250 мг до 1200 мг на день.
Переклад даних з тварин на дози для людей
Миші мають набагато вищий рівень метаболізму, ніж люди, що означає, що вони швидше обробляють речовини. Це вимагає вищих дозувань для досягнення порівнянних ефектів. Пряме перетворення мг/кг з мишей на людей призвело б до нереально високих дозувань. Замість цього дослідники використовують алометричне масштабування для правильного коригування доз.
Приклад: Якщо дослідження на мишах використовує 300 мг/кг, це буде приблизно еквівалентно дозі для людини близько 24 мг/кг при використанні алометричного масштабування. Для середньої дорослої людини вагою 70 кг це перекладається приблизно в 1680 мг щодня. Однак дослідження на людях зазвичай використовують більш консервативні дози з міркувань безпеки.
Скільки NMN приймати загалом?
Ми описали різні рівні дозування NMN, які коливаються від 250 мг до 1200 мг щодня, щоб допомогти вам зрозуміти, з чого почати.
Як і з будь-якою дієтичною добавкою, ви можете очікувати експериментування з дозуванням NMN, поки не знайдете діапазон, який допомагає вам почуватися добре. З нашого особистого досвіду ми рекомендуємо не перевищувати максимальне дозування NMN, яке становить понад 1200 мг.
Хоча добавки NMN пропонують перспективні переваги та є відносно безпечними для здорових людей, все ще важливо персоналізувати ваше дозування NMN на основі ваших потреб та станів здоров’я.
Поради щодо оптимального дозування NMN
✅ Починайте з малого — 250 мг для нових користувачів
✅ Збільшуйте поступово — дайте організму час адаптуватися
✅ Будьте послідовними — приймайте щодня в один і той же час
✅ Слухайте свій організм — коригуйте дозу при необхідності
✅ Не перевищуйте 1200 мг — це максимальна безпечна доза
✅ Консультуйтеся з лікарем — особливо при наявності захворювань
Висновок
Правильне дозування NMN — це індивідуальний процес, який залежить від вашого віку, метаболізму, цілей здоров’я та способу життя. Починайте з 250 мг, якщо ви новачок, і поступово збільшуйте до 500-1000 мг для регулярного прийому. Спортсмени та люди 60+ можуть потребувати 1000-1200 мг, але не перевищуйте цю дозу без консультації з лікарем.
Найважливіше — це регулярність прийому та підбір дозування NMN, яке підходить саме вам. Обирайте якісні добавки від перевірених брендів та насолоджуйтеся перевагами підвищених рівнів NAD+ для здорового старіння! 💊✨
Джерела:
- Shade, C. (2020). The science behind NMN–A stable, reliable NAD+ activator and anti-aging molecule. Integrative Medicine: A Clinician’s Journal, 19(1), 12.
- Yi, L., Maier, A. B., Tao, R., Lin, Z., Vaidya, A., Pendse, S., … & Kumbhar, V. (2023). The efficacy and safety of β-nicotinamide mononucleotide (NMN) supplementation in healthy middle-aged adults: a randomized, multicenter, double-blind, placebo-controlled, parallel-group, dose-dependent clinical trial. Geroscience, 45(1), 29-43.
- Morifuji, M., Higashi, S., Ebihara, S., & Nagata, M. (2024). Ingestion of β-nicotinamide mononucleotide increased blood NAD levels, maintained walking speed, and improved sleep quality in older adults in a double-blind randomized, placebo-controlled study. GeroScience, 1-18.
- University of Waterloo. (2021, March 23). Time of day boosts effectiveness of anti-aging supplements. Waterloo Institute for Nanotechnology. https://uwaterloo.ca/institute-nanotechnology/news/time-day-boosts-effectiveness-anti-aging-supplements
- Mills, K. F., Yoshida, S., Stein, L. R., Grozio, A., Kubota, S., Sasaki, Y., … & Imai, S. I. (2016). Long-term administration of nicotinamide mononucleotide mitigates age-associated physiological decline in mice. Cell metabolism, 24(6), 795-806.

